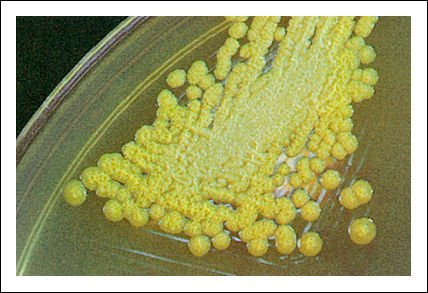

Capítulo 27.
Procariotas y virus
Dentro de la microbiología, la bacteriología y la virología
se ocupan respectivamente de los procariotas y de los virus . Los microorganismos
se caracterizan pos su tamaño diminuto y su alta tasa metabólica.
El alto ritmo de crecimiento y de reproducción, su gran diversidad y
adaptabilidad son ventajas adaptativas importantes a la hora de colonizar nuevos
ambientes: ellos presentan una distribución prácticamente ubicua
en la Tierra. Estas propiedades son también valoradas en la manipulación
en laboratorio y aprovechadas por los sectores agropecuario e industrial, aunque
en el caso de los microorganismos patógenos puedan ser consideradas desventajas.
Los procariotas son los organismos
celulares más pequeños y representan el grupo más antiguo
y más abundante de los seres vivos. La biología molecular ha permitido
a los biólogos identificar dos linajes distintos de procariotas: las
arqueobacterias y las eubacterias.
En años recientes, los
estudios de la ultraestructura y la bioquímica celular -particularmente
de las vías metabólicas-, han permitido a los biólogos
comenzar a desentrañar las relaciones evolutivas entre los procariotas.
Avances decisivos se produjeron gracias al desarrollo de las técnicas
moleculares. Las células procarióticas se caracterizan porque
el DNA asociado a proteínas está en el citoplasma y no hay organelas
limitadas por membranas. En el citoplasma se destaca el nucleoide , donde está
situado el cromosoma . En la membrana celular , que es similar a la de los eucariotas,
se encuentran los sistemas de enzimas ligados a la respiración y a la
fotosíntesis .
El método más
antiguo para identificar a los microorganismos es por su apariencia. Las bacterias
exhiben una considerable diversidad de formas: los cocos, con forma de esfera,
los bacilos, que son como bastones, y los espirilos, que son células
helicoidales. Otra característica es la disposición que adoptan
las células; esto está en relación con los patrones de
crecimiento de cada especie.
La diversidad de formas de los
procariotas está impuesta por la pared celular. Las paredes celulares
de las eubacterias se presentan en dos configuraciones diferentes, que se distinguen
fácilmente por su capacidad para combinarse firmemente con ciertos colorantes.
Se pueden distinguir así las bacterias gram-positivas de las gram-negativas.
Algunas cepas presentan estructuras asociadas a la pared celular como cápsulas,
vainas, fimbrias y flagelos.
La reproducción de los
procariotas es asexual por fisión binaria. La variabilidad genética
se debe principalmente a las mutaciones . También se producen intercambios
y recombinaciones genéticas, que pueden incluso ser interespecíficos,
por otros mecanismos.
Muchos tipos de procariotas
forman esporas duras y resistentes que les permiten sobrevivir en estado latente
durante largos años a condiciones adversas. Algunas especies del dominio
Bacteria producen estructuras especiales llamadas endosporas.
Los procariotas se ditinguen
por presentar distintos requerimientos nutricionales básicos. Muchas
bacterias son quimioorganotrofas; la gran variedad y cantidad de los productos
de las fermentaciones son también aprovechados en la industria. Los quimiolitotrofos
se encuentran solamente entre los procariotas y usan una variedad de sustancias
como donadores de electrones. Los procariotas fotosintéticos, bacterias
verdes y púrpuras, arqueobacterias halófilas y cianobacterias,
carecen de cloroplastos ; en las cianobacterias, los pigmentos fotosintéticos
están incluidos en la membranas.
Aunque conocemos muchas enfermedades
causadas por bacterias, la mayoría no son patógenas y ejercen
una acción benéfica para muchos seres vivos. Su presencia es indispensable
en el mantenimiento del equilibrio ecológico de la Tierra.
Los virus están formados
por ácido nucleico -DNA o RNA- encerrado en una cápside proteica,
en algunos casos rodeada por una envoltura lipoproteica. La reproducción
del virus puede ocurrir solamente dentro de una célula hospedadora; el
ácido nucleico del virus se replica y dirige la formación de nuevas
cápsides proteicas utilizando las enzimas de la célula hospedadora
y otro equipamiento metabólico.
Las enfermedades infecciosas
pueden ser causadas por bacterias, protistas y hongos, así como también
por virus. Las consecuencias de una infección dependen de varios factores,
entre ellos, la invasividad y la toxigenicidad del patógeno.
El universo de los organismos
microscópicos
El tamaño de los microorganismos
no es una característica anodina: además de incidir en su morfología,
actividad, diversidad y flexibilidad en el metabolismo, tiene importantes consecuencias
en su capacidad de adaptación fisiológica, su distribución
ecológica y su manipulación en el laboratorio.
La alta relación superficie
a volumen, típica del diminuto tamaño de estos microorganismos,
es la causa de la alta tasa metabólica que presentan lo cual, a su vez,
está en relación con su rápido ritmo de crecimiento y de
división celular. Muchas de sus enzimas son inducibles, lo cual les resulta
ventajoso debido, entre otras causas, al escaso espacio de que disponen. Los
mecanismos regulatorios desempeñan un papel fundamental, ya que les otorgan
una gran flexibilidad metabólica, y son detectables más fácilmente
que en otros organismos. La elevada relación superficie a volumen implica
extensas interacciones con el entorno y estrategias particulares de adaptación.
Los organismos unicelulares de vida libre se encuentran, de por sí, expuestos
permanentemente a las variaciones ambientales. Éste no es el caso de
los que habitan en medios más constantes o incluso isotónicos,
como es el caso de ciertos parásitos.
Muchos microorganismos son importantes
agentes de enfermedades.
El estudio de las enfermedades
infecciosas y de la forma de combatirlas condujo al estudio de la relación
hospedador-agente infeccioso, a profundizar el conocimiento de los mecanismos
de defensa inmunitarios, y a mejorar y descubrir nuevos métodos de identificación
del agente infeccioso y de diagnóstico de enfermedades. Esto dio origen,
dentro de la microbiología, a distintas ramas tales como la inmunología,
la virología, la bacteriología, la parasitología y la micología
que, desde hace ya tiempo, constituyen vastas disciplinas en sí mismas.
Así, los virus, que según la mayoría de las definiciones
no son seres vivos, por su tamaño microscópico y sus propiedades
causantes de enfermedades son estudiados tradicionalmente por la microbiología.
Los progresos alcanzados en esta área han desembocado en múltiples
aplicaciones, entre ellas, la creación de vacunas, el uso de antibióticos,
el uso de la técnica de esterilización o de métodos desinfectantes.
Además de los microorganismos
causantes de enfermedad, la microbiología también estudia aquellos
que tienen una acción benéfica para el hombre u otros seres vivos.
Es el caso, por ejemplo, de los habitantes naturales del tracto digestivo y
vaginal, de las bacterias y hongos presentes en los quesos, yogures y leches
fermentadas y de las bacterias que viven en relación estrecha con plantas
leguminosas. Así, el desarrollo y las mejoras logradas en las técnicas
de cultivo de los microorganismos no fueron impulsados solamente por el deseo
de combatir las enfermedades por ellos provocadas.
Desde la antigüedad, el
hombre ha aprovechado los productos metabólicos de ciertos microorganismos
para elaborar distintos alimentos sin conocer los mecanismos biosintéticos
ni los propios organismos implicados.
Las bacterias consisten en una sola célula de tipo procariota. Están representados por las arqueobacterias -o bacterias antiguas- y las eubacterias -o bacterias verdaderas-. Los procariotas son el grupo de organismos más antiguo sobre la Tierra; los registros fósiles muestran que se hallan presentes desde hace unos 3.800 millones de años.

Cuadro sinóptico evolutivo: escala de tiempo aproximada, en millones de años, de los acontecimientos que tuvieron lugar en la historia de la vida en la Tierra.
Los primeros seres vivos probablemente fueron termófilos (amantes del
calor) y anaeróbicos (que viven sin oxígeno). En esa época,
la Tierra se encontraba mucho más caliente que en la actualidad y en
la atmósfera no había oxígeno libre.
Desde entonces, estos microorganismos
se han diversificado enormemente y han llegado a ser los organismos más
abundantes.
En cuanto a su nutrición y aprovechamiento de la energía, encontramos todas las alternativas posibles: algunos organismos utilizan la energía proveniente de reacciones químicas mientras que otros son capaces de fotosintetizar; la mayoría utiliza el carbono derivado de compuestos orgánicos y algunos usan el CO2 como fuente de carbono. Con respecto a la respiración celular, no encontramos menos opciones: el oxígeno puede ser vital o letal según el metabolismo de cada bacteria; ciertas especies, incluso, pueden existir con o sin él. Así, algunos procariotas se encuentran entre los escasos organismos modernos que pueden sobrevivir sin oxígeno libre y obtener su energía por procesos anaerobios. Los procariotas pueden sobrevivir en muchos ambientes que no toleran otras formas de vida.
Evolución y clasificación
de los procariotas
La mayoría de las características
usadas para determinar las relaciones filogenéticas entre los eucariotas,
como por ejemplo, las estructuras anatómicas intrincadas y los patrones
complejos de reproducción, desarrollo y crecimiento, simplemente no existen
en los procariotas. Los científicos dedicados al estudio de los procariotas
se veían obligados a basarse en las diferencias fenotípicas, aunque
algunas, tales como la forma de la célula y de las colonias, probablemente
hayan aparecido una y otra vez. Por el contrario, otros aspectos, como la capacidad
de fotosintetizar o de formar esporas, se han perdido independientemente en
varios linajes. Muchas de estas características no reflejan entonces
relaciones filogenéticas.
Basados en el análisis
comparativo de secuencias del RNA ribosomal se han establecido tres linajes
celulares -o dominios - distintos: Archaea, Eukarya y Bacteria. Sólo
uno de estos linajes, Eukarya, es eucariota. A pesar de que Archaea y Bacteria
son estructuralmente procariotas, a nivel molecular son evolutivamente tan diferentes
uno de otro como cada uno lo es de Eukarya. Se piensa que los tres grupos derivan
de un organismo ancestral común: "el ancestro universal". Los
distintos linajes evolutivos que forman parte de los dominios Bacteria y Archaea
se determinaron también por análisis del rRNA. Actualmente, el
dominio Archaea, correspondiente a las arqueobacterias, comprende los reinos
Crenarchaeota, Euryarchaeota y Korarchaeota, aunque este último es aún
discutido.
El dominio Bacteria, correspondiente a las eubacterias, comprende por lo menos doce linajes evolutivos distintos o reinos.

Esquema global de las relaciones evolutivas de los seres vivos.

Árbol filogenético derivado del análisis comparativo de secuencias del rRNA 16S de los procariotas Archaea

Dominio Bacteria.
Las distancias evolutivas relativas entre los dominios y este ancestro universal
están aún en discusión. Dentro de los dominios Archaea
y Bacteria se muestran algunos representantes de los reinos, los linajes evolutivos
que derivan de cada dominio, de acuerdo con los estudios más recientes.Las
eubacterias que son fotosintéticas incluyen a las cianobacterias, las
bacterias verdes y muchas de las bacterias púrpura. Íntimamente
relacionadas con las bacterias púrpura hay muchas formas no fotosintéticas
familiares que incluyen a E. coli y al género Pseudomonas.
Las relaciones filogenéticas
entre los procariotas emergieron a partir de análisis genotípicos,
pero la taxonomía bacteriana se basa tradicionalmente en análisis
fenotípicos. Así, a diferencia de otros organismos, la filogenia
y la taxonomía bacterianas no son equivalentes.
En cuanto a la identificación
de las especies, en la taxonomía bacteriana ciertos caracteres son de
particular importancia: la morfología de lascolonias,
la morfología de las células, su tinción con distintos
colorantes, la movilidad, la presencia o ausencia de estructuras celulares,
las condiciones de cultivo, los parámetros de crecimiento, el metabolismo,
la resistencia a antibióticos y el porcentaje de ciertas bases nitrogenadas.
A pesar de que los caracteres fenotípicos han provisto de poca información a la filogenia bacteriana, continúan siendo de gran utilidad y de uso rutinario en el diagnóstico y tratamiento médico y veterinario, en la agricultura y en la microbiología industrial. Por eso, para nuestros propósitos, el examen de las características de los organismos procariotas es la mejor introducción a su diversidad.
En la figura se observan colonias mucosas de Pseudomonas cepacia.
Las colonias de la figura son bacilos gram-negativos, aerobios, que pueden producir
infecciones pulmonares y urinarias, y son muy resistentes a antibióticos.
La célula procariótica
Al observar la célula
se destaca una región densa -el nucleoide-, donde está situado
el cromosoma §. Todos los cromosomas de los procariotas consisten en una
sola molécula circular de DNA que puede estar asociada con una pequeña
cantidad de RNA y proteínas no histónicas. También, puede
haber uno o más plásmidos. Los estudios del cromosoma procariótico
han contribuido enormemente a nuestro conocimiento de los mecanismos genéticos.
El citoplasma de los procariotas
carece de citoesqueleto. A menudo, tiene una apariencia granular fina, debida
a sus muchos ribosomas que, aunque son un poco más pequeños que
los de los eucariotas, tienen la misma configuración general. El citoplasma
no contiene núcleo ni organelas y no está dividido en compartimientos
por membranas, excepto en las cianobacterias que, como veremos, contienen un
extenso sistema de membranas donde se hallan los pigmentos fotosintéticos.
Diversidad de formas
Las bacterias exhiben una considerable diversidad de formas, pero entre las más frecuentes distinguimos: los denominados cocos, que tienen forma de esfera, los bacilos como Escherichia coli, que son como bastones de longitud variable de extremos redondeados, y los espirilos, que son células helicoidales. Algunas variantes de estas formas son los cocobacilos (óvalos) y las bacterias corineformes, bacilos irregulares con un extremo ensanchado. Menos frecuentes son los vibriones, con forma de coma (cortos bastones encorvados). El más conocido es Vibrio cholerae, agente causante del cólera.

Los bacilos de Clostridium botulinum, causante de intoxicaciones alimentarias graves, secretan una toxina mortal.
Las formas abultadas que se observan en la figura son estructuras de resistencia
que le permiten sobrevivir en condiciones adversas. También tienen forma
de bacilos las bacterias que causan difteria (Corynebacterium diphtheriae) y
tuberculosis (Mycobacterium tuberculosis), así como la familiar E. coli.

Estas minúsculas células de Micrococcus luteus tienen forma de cocos como muchas otras bacterias.
Entre las bacterias con forma de cocos se encuentra Streptococcus pneumoniae,
uno de los agentes causantes de la neumonía bacteriana; Streptococcus
lactis, que se usa en la producción comercial de queso, y Nitrosococcus,
bacteria del suelo que oxida amoníaco a nitrato.

Las espiroquetas del género Leptospira
Las espiroquetas infectan muchos animales salvajes y pueden transmitirse al
hombre a través de las ratas causando leptospirosis.
La espiroqueta de la figura
mide 500 micrómetros de largo, que es un tamaño enorme para un
procariota. El Treponema pallidum, otra espiroqueta, es el agente causante de
la sífilis. Los espirilos enrollados helicoidalmente son menos comunes
que los cocos y los bacilos. Con la excepción de algunas especies que
pueden exhibir formas celulares distintas, la forma de las células es
característica de cada especie bacteriana.
Otra característica es
la disposición que adoptan las células; esto está en relación
con los patrones de crecimiento de cada especie. Los cocos, por ejemplo, después
de dividirse, pueden quedar dispuestos de a pares ("diplococos"),
en racimos ("estafilococos") o pueden formar cadenas ("estreptococos").
Staphylococcus aureus, por ejemplo, produce infecciones caracterizadas por forúnculos
o abscesos pero, dentro del género Staphylococcus, y de la familia Micrococcaceae,
sólo tres especies son de importancia médica. Los bacilos habitualmente
se separan después de la división celular. Cuando no es así,
como se dividen por el plano transversal, quedan unidos por los extremos formando
filamentos. En algunos géneros, estos filamentos son de aspecto de moho,
y el prefijo mico -del griego myco (hongo)- forma parte del nombre genérico.
Este es el caso de Mycobacterium tuberculosis, el bacilo causante de la tuberculosis.
Este tipo de asociaciones no significan, sin embargo, multicelularidad: todas
las células son completamente viables e independientes.
Morfología de las células
bacterianas
La composición química
de la membrana de las eubacterias es similar a la de una célula eucariótica:
los ácidos grasos son generalmente lineales y la unión entre ellos
y el glicerol es de tipo éster. Esta es una característica de
los dominios Bacteria y Eukaria. Sin embargo, las membranas bacterianas carecen
de colesterol u otros esteroides excepto en los micoplasmas (las células
más pequeñas de vida libre). Por el contrario, los lípidos
de la membrana de las arqueobacterias están formados por hidrocarburos
largos y ramificados que se unen al glicerol por una unión de tipo éter.
Éste es uno de los criterios no genéticos más usados para
diferenciar a los tres dominios. En los procariotas aerobios, en la membrana
celular se ubican las moléculas transportadoras de electrones de la cadena
respiratoria. En las bacterias fotosintéticas, pero no en las cianobacterias,
en la membrana también se encuentra la maquinaria fotosintética.
La membrana contiene, además, sitios de unión específicos
para las moléculas de DNA que asegurarían la separación
de los cromosomas replicados durante la división celular.
Casi todos los procariotas están
rodeados por una pared celular que da a la célula su forma característica.
En algunos casos, la pared es flexible pero, en general, es rígida. Dado
que la mayoría de las bacterias son hipertónicas en relación
con su ambiente, estallarían si no tuviesen pared.
La pared celular de cada uno
de los dos linajes procariotas tiene una composición particular que es,
a su vez, distinta de la que poseen los eucariotas.
El tipo de tinción celular, como resultado del uso de ciertos colorantes, es uno de los caracteres fenotípicos que hemos mencionado para la identificación de las bacteriasLa coloración de Gram es de uso prácticamente universal para la identificación de eubacterias y refleja una diferencia fundamental en la arquitectura de la pared celular de las eubacterias.

Esquemas de las paredes celulares de eubacterias gram-positivas (G+) y gram-negativas (G-).
a) La pared de las G+ consta de sólo una capa de 10 a 80 nm de espesor
de peptidoglicano. b) La pared de las G- consta de una capa de 2 a 3 nm de espesor
de peptidoglicano, el periplasma y una membrana externa de 7 a 8 nm de espesor
con lipoproteínas y lipopolisacáridos de estructura similar a
la membrana celular.
Algunas bacterias, por fuera
de la pared celular, secretan una cápsula de polisacáridos viscosa.
La cápsula sirve de protección contra la desecación y los
materiales tóxicos, promueve la concentración de nutrientes en
la superficie de la célula y participa en la adherencia celular. Aunque
en general su presencia no es vital para la bacteria, durante una infección
la puede proteger del sistema inmune del hospedador y aumentar así su
virulencia.
Algunas bacterias presentan otras sustancias en su superficie externa, además de las cápsulas. Por ejemplo, las células de muchas cianobacterias y de las bacterias deslizantes, grupo no fotosintético, forman estructuras filamentosas que secretan una baba o moco.

Oscillatoria, una cianobacteria filamentosa.
Aunque muchas cianobacterias son no-móviles, las formas filamentosas
típicamente se deslizan sobre un mucílago secretado por las células.
Como se puede imaginar dado su color verde, todas las cianobacterias son fotosintéticas.

Filamentos de células de una cianobacteria de agua dulce del género Anabaena.
Cuando la concentración
de nitratos es muy pequeña, ciertas células, como las dos más
grandes del filamento, se diferencian y se especializan en células que
no realizan fotosíntesis sino que fijan el nitrógeno de compuestos
orgánicos.
Algunas bacterias tienen extensiones largas, delgadas, conocidas comúnmente como flagelos, y pelos que son de composición y función diferentes. Los flagelos bacterianos son responsables de la movilidad y, según las especies, pueden aparecer como penachos, de número variable, en uno o en los dos polos de la célula; también pueden estar distribuidos en toda su superficie. Se encuentran más a menudo en las bacterias gram-negativas y están constituidos por tres partes: el filamento, el gancho y el cuerpo basal.

Diagrama de la ultraestructura de un flagelo.
El cuerpo basal, que sirve para amarrar el flagelo, está formado por
dos pares de anillos que rodean un bastón. Los anillos M, S, P y L están
integrados en la membrana celular, el espacio periplasmático, el peptidoglicano
y los lipopolisacáridos de la membrana externa. En las bacterias gram-positivas
sólo existen los anillos M y P. El filamento está constituido
por subfibrillas de flagelina que forman una hélice con un centro hueco.
Las variaciones en el diámetro (13 a 17 nanómetros según
las especies) probablemente corresponda a la composición específica
de la flagelina.
Las fimbrias son apéndices
con aspecto de pelos que están presentes, en número variableen
las bacterias gram-negativas sean o no flageladas. Las fimbrias, que parecen
tener origen en la membrana celular; carecen de cuerpo basal y de gancho. Participan
en la formación de pares específicos durante la conjugación
y sirven de sitio de adhesión de virus bacterianos.
Reproducción y variabilidad
genética
Los procariotas se reproducen
típicamente por fisión binaria. Una célula "madre"
duplica su material genético y celular que se reparten equitativamente
dando lugar a dos células "hijas" genéticamente idénticas
a la original. Se trata de una reproducción asexual. Luego de numerosas
multiplicaciones a partir de una célula, se obtiene un clon o colonia
de células iguales. En este caso, los genes se transfirieron verticalmente,
de generación en generación de la célula madre a las células
hijas.
Este esquema puede alterarse
si se producen mutaciones que constituye la mayor fuente de variabilidad genética
de los procariotas.
Al ser los procariotas básicamente
haploides, las mutaciones pueden expresarse más rápidamente y
ser así también seleccionadas. Las mutaciones y el corto tiempo
de generación de los procariotas son, en gran medida, responsables de
su extraordinaria capacidad de adaptación y diversidad. Además,
esto ha permitido realizar avances notables en la genética.
Otras fuentes adicionales de
variabilidad genética en los procariotas están dadas por la conjugación,
la transformación y la transducción. Aunque estos mecanismos difieren
bastante de los implicados en la reproducción sexual de los eucariotas
§, todos permiten la transferencia, y la recombinación genética.
En los tres mecanismos mencionados,
se trata de una transferencia horizontal (o lateral) de genes que habitualmente
se produce entre organismos de una misma especie. Aunque en los procariotas
existen barreras (tales como enzimas de restricción, receptores y otras
estructuras de membrana específicas) a la entrada de DNA exógeno
y a su recombinación con el DNA propio, en algunos casos se producen
"fallas" y, como consecuencia, ocurren intercambios genéticos
interespecíficos. Estas recombinaciones pueden acarrear serias dificultades
y confusiones cuando se trata de establecer el origen filogenético de
algún taxón.
Formación de endosporas
Algunas especies del dominio
Bacteria producen estructuras especiales llamadas endosporas. Se trata de células
diferenciadas con características fenotípicas propias. Las características
más sobresalientes son: 1) su extraordinaria resistencia, sobre todo
al calor, pero también a la desecación, a las radiaciones, a ácidos
y a desinfectantes químicos y 2) su perdurabilidad: pueden permanecer
años "en reposo" pero continuar siendo viables.
Nutrición y metabolismo
de los procariotas
De acuerdo con los requerimientos nutricionales básicos, encontramos cuatro categorías fundamentales de procariotas. En cuanto a la fuente de energía utilizada, los organismos que utilizan la luz se denominan fotótrofos y los que obtienen la energía a partir de la oxidación de compuestos químicos se llaman quimiotrofos. Del mismo modo, como fuente de carbono, los organismos pueden utilizar compuestos inorgánicos, como el CO2.Estos organismos se denominan litotrofos. Si utilizan compuestos orgánicos -el más universalmente utilizado es la glucosa- se denominan organotrofos. A los fotótrofos también se los conoce como autótrofos (se bastan a sí mismos) en contrapartida con los heterótrofos cuyos compuestos orgánicos derivan de los procesos anabólicos de otros seres vivos.

Los virus: unidades de información
genética
Los virus están formados
por una región central de ácido nucleico, DNA o RNA, rodeado por
una cubierta de proteína o cápside y, en algunos casos, por una
envoltura lipoproteica. Se reproducen solamente dentro de las células
vivas, apoderándose de las enzimas y de la maquinaria biosintética
de sus hospedadores. Sin esta maquinaria, serían tan inertes como cualquier
otra macromolécula, o sea, sin vida según la mayoría de
los criterios. Los virus difieren entre sí en su tamaño, forma
y composición química de su genoma. Estas características
son utilizadas para su identificación y clasificación. En las
primeras etapas de la virología, los virus se clasificaban según
su patogenicidad, su presencia en determinados órganos o el modo en que
se transmitían. El advenimiento de nuevas técnicas, como la microscopía
electrónica, permitió visualizar directamente las partículas
virales -o viriones- y determinar de este modo, en forma más precisa
su forma y tamaño.
En los siguientes esquemas se muestran varias estructuras virales representativas.

Adenovirus, uno de los muchos virus que causan los resfríos en los humanos.
Este virus es un icosaedro. Cada uno de sus veinte lados es un triángulo
equilátero, compuesto por idénticas subunidades proteicas. Muchos
virus están constituidos sobre este principio. Hay 252 subunidades en
total. Dentro del icosaedro, se encuentra el genoma viral de DNA de doble cadena.

Modelo del adenovirus, generado por computadora.

Fotomicrografía electrónica del virus de la influenza o gripe.
El virus está compuesto por un genoma segmentado en 8 moléculas
de RNA de cadena simple, que se asocian con moléculas de una proteína
que le confieren forma helicoidal. Los RNA genómicos asociados con la
proteína reciben el nombre de nucleocápsides. Rodeando las nucleocápsides,
existe una membrana lipoproteica a través de la cual emergen las glucoproteínas
virales de envoltura (neuroaminidasa y hemaglutinina). El virus de la influenza
muta frecuentemente. Los cambios en su ácido nucleico alteran las proteínas
de la envoltura externa y, por lo tanto, los anticuerpos previamente formados
ya no lo "reconocen". Es probable que surjan nuevas cepas de virus
de influenza más rápidamente que las vacunas que puedan producirse
para combatirlas.

Diagrama del virus de la gripe.

Fotomicrografía electrónica de un bacteriófago Tpar, mostrando sus muchos componentes estructurales diferentes.
El DNA del virus codifica todas las proteínas necesarias. La cabeza de
la cápside, las estructuras más importantes de la cola y las fibras
de la cola se ensamblan por separado. Después de que el DNA ha sido insertado
en la cabeza de la cápside, el ensamble de la cola preformada se une
a ella. La adición de las fibras de la cola completa la partícula
viral.

Diagrama de un bacteriófago Tpar.
Por otra parte, los avances de la biología molecular, aportaron nuevas
herramientas para la clasificación de los virus, según las características
de sus genomas. El genoma de los virus puede estar constituido por DNA o RNA
de cadena simple o doble. Las proteínas de la cápside pueden tomar
distintas formas. La cápside puede estar rodeada por capas adicionales
o tener otras estructuras proteínicas complejas unidas a ella. Algunos
virus poseen, además, una envoltura lipídica, proveniente de la
célula infectada, en la que están insertadas proteínas
virales. La mayor parte de esas proteínas están glucosiladas y
se denominan glucoproteínas de envoltura.
Las proteínas de la cápside
o las proteínas de envoltura determinan la especificidad de un virus;
una célula puede ser infectada por un virus si la proteína viral
puede "encajar" en uno de los receptores específicos de la
membrana celular de ese tipo de célula.
Aparentemente, todos los tipos
de células, tanto procarióticas como eucarióticas, son
susceptibles de infección por virus específicos capaces de establecer
una interacción con sus receptores de membrana.
En algunas infecciones virales,
la cubierta proteínica queda fuera de la célula, mientras que
el ácido nucleico entra al citoplasma. En otras, el virus intacto entra
a la célula pero, una vez dentro, la cápside se desensambla por
distintos mecanismos, liberando el ácido nucleico viral. Luego, el genoma
viral comienza a transcribirse y a replicarse y forma nuevas partículas
virales. La estrategia que utilizan los virus para multiplicarse varía
de acuerdo al tipo de virus, lo que determina, a su vez, el lugar dentro de
la célula en que se replica y transcribe su genoma.
En los virus con genoma de DNA,
el DNA del virus se replica y también se transcribe a RNA mensajero (mRNA).
El mRNA codifica enzimas virales, proteínas de la cubierta viral y, en
algunos casos, proteínas reguladoras que controlan la expresión
del genoma de la célula hospedadora. El virus realiza sus actividades
biosintéticas con el equipamiento de la célula hospedadora. Muchos
virus usan enzimas del hospedador al igual que las codificadas por sus propios
ácidos nucleicos; algunos fragmentan el DNA del hospedador y reciclan
los nucleótidos para la síntesis del DNA viral. En la mayoría
de los virus de RNA, el RNA viral se replica y actúa directamente como
mRNA. Otros en cambio, llevan en la partícula viral una enzima propia
que les permite sintetizar los mRNA, usando como molde el RNA genómico,
ya que éste no puede funcionar como mensajero.
En otro tipo de virus de RNA,
el RNA viral se transcribe a DNA a partir del cual se transcribe luego el mRNA.
Este fenómeno de transcripción inversa es característico
de los retrovirus, tanto de los que causan cáncer, como del virus HIV,
responsable del SIDA (síndrome de inmunodeficiencia adquirida).
Las partículas virales
se ensamblan dentro de la célula hospedadora. Los virus recién
formados surgen como brotes en porciones de la membrana de la célula
hospedadora que contienen las proteínas virales y, al hacerlo, quedan
envueltos por fragmentos de ella.
Cuando se ha completado el ensamble
de partículas virales, éstas se desprenden de la célula
hospedadora, a menudo provocando la lisis de su membrana en el proceso. Cada
nueva partícula viral es capaz de comenzar un nuevo ciclo de infección
en una célula no infectada.
El estudio del origen y de la
evolución de los virus se ve dificultado por la falta de restos fósiles.
Los síntomas de enfermedades virales que conocemos actualmente pueden
ser rastreados sólo hacia el comienzo de los registros de la historia
humana.
Para realizar estudios comparativos,
sólo disponemos de virus aislados hace no más de 80 años.
Por lo tanto, para elaborar una hipótesis sobre el origen de los virus,
solo podemos hacer extrapolaciones hacia atrás, basándonos en
el estudio detallado de las características de los virus actuales.
Existen tres teorías
principales que explicarían el origen de los virus. Una de ellas, la
teoría regresiva, propone a los virus como formas degeneradas de parásitos
intracelulares. Otra teoría postula que los virus se habrían originado
a partir de componentes celulares normales (DNA o RNA) que habrían adquirido
la capacidad de replicarse en forma autónoma y de evolucionar independientemente.
La tercera teoría se
relaciona con la hipótesis de un mundo prebiótico basado en RNA.
Han sido aislados e identificados
otros agentes infecciosos aun más simples que los virus: los viroides
(pequeñas moléculas de RNA sin proteínas asociadas) y los
priones. Los viroides son el agente causal de ciertas enfermedades de las plantas
y los priones transmiten enfermedades neurodegenerativas llamadas encefalopatías
espongiformes. No se conocen los mecanismos por los cuales los viroides ejercen
sus efectos patogénicos, pero una hipótesis sugiere que estos
elementos interfieren con la regulación génica de las células
infectadas.
Cómo causan enfermedad
los microorganismos
La mayoría de las veces,
los microorganismos potencialmente patógenos viven dentro de los organismos
hospedadores sin que aparentemente causen efecto alguno. El éxito evolutivo
se mide en términos de progenie que sobrevive. Un microorganismo que
destruye a su hospedador antes de reproducirse y dispersar su progenie a nuevos
hospedadores tiene menos probabilidad de ser exitoso, según el criterio
evolutivo, que uno que mantiene una larga y confortable relación con
su protector. Así, la enfermedad puede ser el resultado de un cambio
repentino en el microorganismo, en el hospedador o en la relación.
Los efectos patógenos
de los microbios son producidos por diversos mecanismos. Los virus penetran
en tipos particulares de células y, a menudo, las destruyen. Las bacterias
también pueden producir lisis celular. Para el hospedador, las consecuencias
de una infección dependen de varios factores. Uno de ellos es la invasividad
del patógeno, es decir, su habilidad para multiplicarse dentro del cuerpo
del hospedador. Sin embargo, los síntomas de la enfermedad, a menudo,
no son causados por la acción directa de los patógenos, sino por
toxinas o venenos producidos por ellos. El factor que interviene, entonces,
es la toxigenicidad. Existen dos tipos de toxinas: las endotoxinas y las exotoxinas.
Las endotoxinas son lipopolisacáridos
asociados con la membrana externa de las bacterias gram-negativas; su toxicidad
reside en su parte lipídica. Cuando la bacteria muere (se lisa), estos
lípidos se unen a las células del sistema inmunitario y causan
fiebre y otros síntomas que denotan la infección. Salmonella y
Escherichia incluyen especies que producen endotoxinas. Las exotoxinas son secretadas
al medio por las bacterias. Entre las bacterias que producen exotoxinas se encuentran
las que causan el tétano (Clostridium tetani), el botulismo (Clostridium
botulinum) y el cólera (Vibrio Cholerae).
Algunas enfermedades son el
resultado de la reacción del cuerpo al patógeno. En la neumonía,
causada por el Streptococcus pneumoniae, la infección provoca una sobreproducción
de líquido y de células en los sacos aéreos de los pulmones,
que interfiere con el proceso respiratorio. Los síntomas de las infecciones
por hongos en la piel resultan análogamente de respuestas inflamatorias.
Un solo agente puede causar
distintas enfermedades. Las infecciones en la piel por Streptococcus pyogenes
causa el impétigo mientras que en la garganta causan la faringitis estreptocócica.
La escarlatina es el resultado de la infección en la garganta con cepas
que producen toxinas (como resultado de la acción de un bacteriófago).
Inversamente, muchos agentes
distintos pueden causar los mismos síntomas: el "resfrío
común" puede ser el resultado de una infección provocada
por un gran número de virus, así como la pneumonía puede
tener varios agentes causales distintos (virales y bacterianos).
Muchas enfermedades infecciosas,
tanto bacterianas como virales, pueden ser evitadas por inmunización.
El uso de las vacunas, por ejemplo, ha permitido prácticamente erradicar
ciertas enfermedades, como la poliomielitis, que causaban estragos en otras
épocas.
Las bacterias son sensibles
a drogas antimicrobianas como los antibióticos; entre ellos, el más
conocido es la penicilina. Las drogas antimicrobianas hicieron posible no sólo
el tratamiento de heridas de guerra y de enfermedades infecciosas comunes, sino
también el uso generalizado y, a menudo, salvador de vidas de la cirugía
mayor. Por otra parte, la búsqueda de antivirales se orienta al desarrollo
de drogas que impidan la entrada del virus a la célula o que bloqueen
el ciclo de replicación viral en alguna de sus etapas, ya sea la síntesis
de nuevos genomas o la formación de nuevas partículas virales.